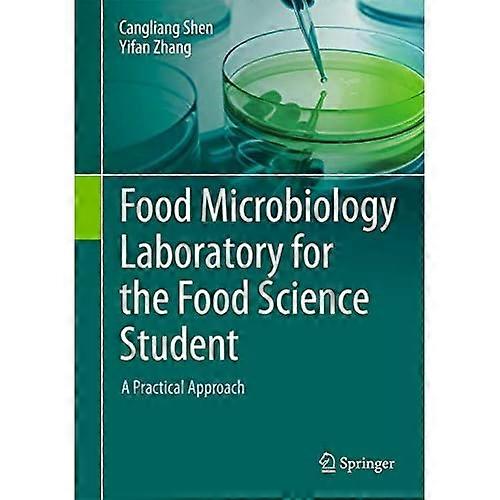

Food Microbiology Laboratory for the Food Science Student: a Practical Approach
+ NOK 67,49 i frakt
Food Microbiology Laboratory for the Food Science Student: a Practical Approach
- Merke: Unbranded
Food Microbiology Laboratory for the Food Science Student: a Practical Approach
- Merke: Unbranded
| Pris: |
Kun 3 igjen på lager
Vi godtar følgende betalingsmetoder
Beskrivelse
- Merke: Unbranded
- Kategori: Science Fiction & fantasi
-
Lengde: 103 Pages
-
Format: Paperback
-
Størrelse : 254 mm 178 mm
-
Forlag / Selskap: Springer International Publishing A&G
-
Publiseringsdato: 2017
-
Forfatter: Cangliang Shen, Yifan Zhang
-
Språk: English
- Fruugo-ID: 337207302-740822117
- ISBN: 9783319583709
Levering og retur
Sendes i løpet av 2 dager
-
STANDARD: NOK 67,49 - Levering mellom kl ons. 15 oktober 2025–fre. 24 oktober 2025
Sendes fra Storbritannia.
Vi gjør vårt beste for å sikre at produktene du bestiller, leveres til deg i sin helhet og i samsvar med dine spesifikasjoner. Skulle du likevel motta en ufullstendig bestilling eller andre varer enn dem du bestilte, eller hvis du av en eller annen grunn ikke er fornøyd med bestillingen, kan du returnere bestillingen eller enkeltvarer i bestillingen og motta full refusjon for varene. Se fullstendige retningslinjer for retur